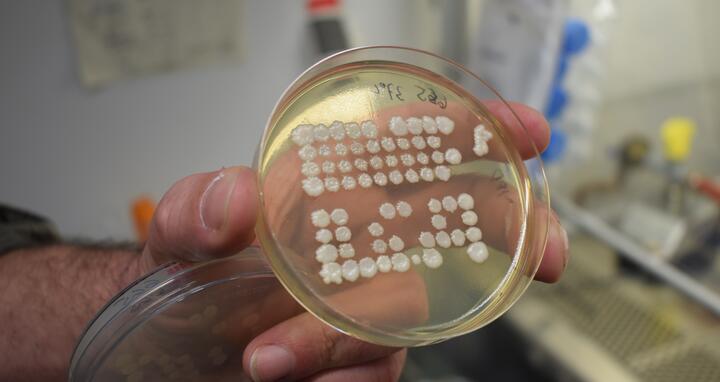
samt-0
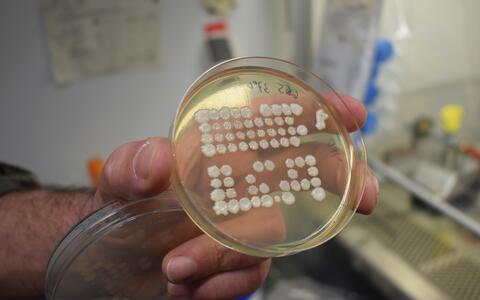
samt-0-1
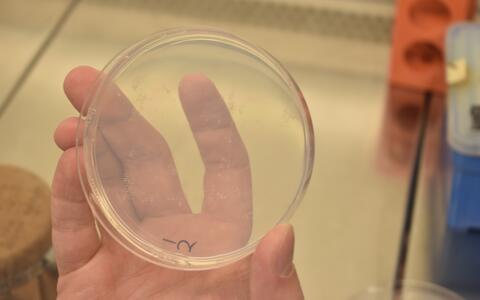
samt-4-1

#LabHacks: Der Übertragungskünstler
Behutsam streicht Ernst Jarosch über das bräunliche Stück Stoff, das aus seiner Aluminium-Verpackung lugt. Es sieht ein wenig verschlissen aus, an den Rändern sind einige durchgewetzte Stellen erkennbar. „Unsere Samtstücke werden regelmäßig gewaschen und autoklaviert, das hinterlässt auf Dauer Spuren“, sagt der Forscher aus der Arbeitsgruppe von Thomas Sommer. Gut möglich, dass die Samtzuschnitte, die in seinem Labor genutzt werden, zu den ältesten verwendeten Laborutensilien des MDC gehören. Corinna Volkwein, die technische Assistentin der Arbeitsgruppe, hat den Samt vor 24 Jahren in einem Stoffladen erstanden.
Der Wissenschaftler und seine Kollegen nutzen die Samtzuschnitte, um Mikroorganismen von einer Platte mit Nährboden auf eine andere zu übertragen. Auf diesen Platten wachsen Hefepilz-Kolonien, deren Gene sich voneinander unterscheiden. Besitzt eine Kolonie ein bestimmtes Gen, kann sie auf manchen Nährmedien wachsen, auf anderen jedoch nicht. So ein Gen kann der Hefe zum Beispiel eine Resistenz gegen ein bestimmtes Antibiotikum verleihen. Ist dieses Antibiotikum dem Medium zugesetzt, wachsen darauf nur die Hefen mit dem passenden Resistenzgen .
Im Experiment kreuzen die Forscher zuerst Hefen mit unterschiedlichen genetischen Eigenschaften miteinander und vergleichen dann das Wachstum der Kolonien auf Nährplatten mit unterschiedlichen Zusätzen. Hier kommt der weiche Stoff ins Spiel. „Samt ist dafür gut geeignet, denn er hat eine raue Oberfläche, auf der die Zellen haften bleiben und sich auf die nächste Platte übertragen lassen. So ist der Aufwand deutlich geringer, als alles einzeln zu testen“, berichtet Christian Lips, Doktorand in der Arbeitsgruppe. Er drückt eine kolonienbewachsene Platte auf einen gleichgroßen, mit Samt bezogenen Kunststoffblock. Auf diesen Abdruck bringt er anschließend mehrere „frische“ Nährmediumsplatten auf, die nun, gut erkennbar, jede einen zarten Abdruck aus Hefezellen aufweisen. Aus dem Wachstumsverhalten auf diesen Platten – wie gut wachsen die Kolonien, oder wachsen sie gar nicht? – kann er wiederum auf den Genotyp, also auf die Kombination der untersuchten genetischen Eigenschaften, rückschließen.
Nicht jeder x‑beliebige Samt eignet sich für den Einsatz im Labor: Als Ernst Jarosch vor einigen Jahren neuen Stoff besorgte, musste er feststellen, dass dessen Qualität nicht ausreichend war. Der neue Samt fusselte und wurde bald wieder aussortiert. Zum Glück hält der Samt-Oldie immer noch, vielleicht ja für weitere 24 Jahre.
Beitragsbilder: Redaktion, MDC